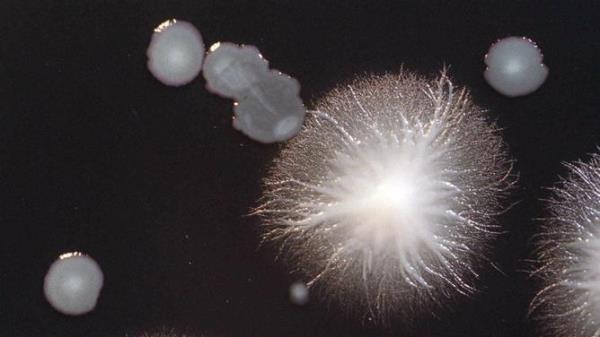
Legio<em></em>nella bacteria at Victorian Infectious Diseases Reference Laboratory 01 May 2000. <em></em> legio<em></em>nnaires disease

在多人因严重问题入院治疗后,卫生当局发布了一种危险疾病的紧急警告。
维多利亚州卫生部透露,自上周五以来,墨尔本各地的退伍军人病病例“大幅增加”,他们正在调查退伍军人病的爆发。
在过去三天里,已有22例确诊病例,另有6例疑似病例。
大多数病例发生在40岁以上的成年人中,其中许多人因严重肺炎需要住院和重症监护。
卫生当局目前正在寻找疫情的源头。
军团病可引起胸部感染,症状包括发烧、发冷、咳嗽、头痛和肌肉酸痛。其他非典型症状可能包括恶心、呕吐、腹泻和精神错乱,”卫生部在一份声明中说。
“所有病例都去过或居住在墨尔本大都会。
“风险最大的是40岁以上的成年人,尤其是有其他疾病或免疫缺陷的人,或者吸烟的人。”
任何出现症状的人都被敦促寻求紧急医疗护理。
对患有该病的人进行的检测结果表明,墨尔本的疫情是由“嗜肺军团菌血清1组”引起的,可以通过单一抗原试验检测到。
疫情的来源尚不清楚,但正在进行调查以确定其来源。

这种细菌存在于盆栽混合料和土壤中,通常在袋装盆栽混合料、地膜和其他产品中繁殖,在接触这种细菌后10天内就会出现症状。
它也存在于河流、湖泊、小溪和温泉,以及水疗和温水系统中。
军团病的一个更常见的来源是由一种不同的细菌引起的,这种细菌通常在大型建筑物中被污染的空调冷却系统中发现。
军团病是通过吸入含有军团菌的细小水滴传播的。
它通常不会在人与人之间传播,也不会通过饮用受污染的水传播。
卫生部敦促任何在墨尔本大都会及周边地区居住、工作或访问过该地区的人,如果出现症状,应寻求紧急医疗护理。
健康专家在墨尔本爆发军团病时发出紧急警告



